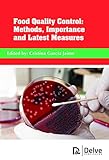
Amazon cover image

Food Quality Control : Methods, Importance and Latest Measures / edited by Cristina Garcia Jaime
Material type: TextPublication details: Oakville, Canada : Delve Publishing, c2018.Description: 289 pages : color illustrations ; 25 cmContent type:
TextPublication details: Oakville, Canada : Delve Publishing, c2018.Description: 289 pages : color illustrations ; 25 cmContent type: - text
- unmediated
- volume
- 9781773610191
- TP 370 F66 2018
| Item type | Current library | Shelving location | Call number | Status | Date due | Barcode |
|---|---|---|---|---|---|---|
 Book
Book
|
TUP Manila Library | New Acquisitions-Ground floor | TP 370 F66 2018 (Browse shelf(Opens below)) | Available | P00031898 |
Includes bibliographical reference and index.

There are no comments on this title.